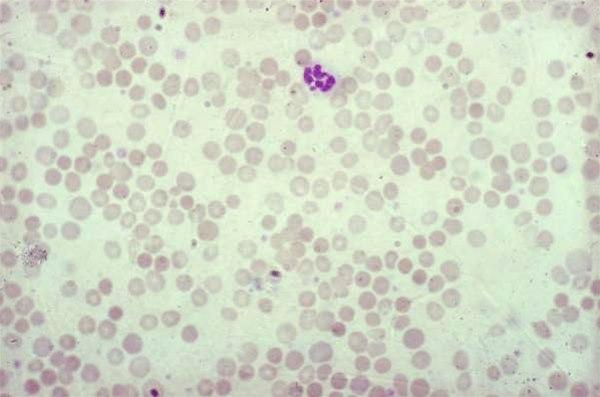

Anemi, lav blodprosent
Anemi kan ha en rekke ulike årsaker. Vanlige symptomer er slapphet, blekhet, kortpusthet, hurtig puls, svimmelhet, kalde hender og føtter, og hodepine.

Sist oppdatert:
18. jan. 2021
Hva er anemi?

Anemi betyr at du har for få friske røde blodceller. Det medfører at mengden av det oksygenbindende proteinet hemoglobin (Hb) som befinner seg inne i de røde blodcellene, blir lavt. Hemoglobin er det stoffet som sørger for oksygentransporten i blodet fra lungene og ut i alle kroppens vev. Det er mengden hemoglobin som måles, når vi sier vi måler "blodprosenten". Normalverdien av Hb varierer med alder og kjønn. Det er mange ulike årsaker til at anemi oppstår, men tap av blod er den hyppigste årsaken.
Verdens Helseorganisasjon definerer anemi som hemoglobin:
- lavere enn 13,0 g/dL hos menn eldre enn 15 år og kvinner etter overgangsalderen
- lavere enn 12,0 g/dL hos kvinner i fertil alder over 15 år og barn 12-14 år
- lavere enn 11,5 g/dL hos barn i alderen 5 til 11 år
- lavere enn 11,0 g/dL hos gravide kvinner og barn under 5 år
Lav kapasitet på oksygentransport fører til slapphet, dårligere kondisjon og nedsatt maksimal yteevne.
Årsaker til anemi
Det er mange årsaker til at blodet ditt inneholder for få røde blodceller. Det kan skje hvis
- kroppen din ikke produserer nok røde blodceller
- blødning gjør at du mister røde blodceller raskere enn kroppen klarer å produsere nye
- kroppen destruerer røde blodceller for raskt, cellene har kortere enn normal levetid
Kroppen lager tre typer blodceller:
- Hvite blodceller som bekjemper infeksjoner.
- Blodplater som hjelper til å danne blodpropper og stanse blødninger.
- Røde blodceller som frakter oksygen ut i kroppen.
De røde blodcellene inneholder hemoglobin, et rødt, jernrikt protein som gir blodet dets røde farge. Hemoglobin gjør de røde blodcellene i stand til å bringe oksygen fra lungene til alle deler av kroppen, og til å bringe avfallsstoffet karbondioksyd fra alle cellene til lungene der det pustes ut.
De fleste røde blodceller produseres kontinuerlig i beinmargen - et rødt, svampaktig vev som finnes inne i de mange hulrommene som finnes inne i de store/lange bena. Der utvikles de fra stamceller til ferdige røde blodceller på 7 dager, og de ferdige cellene har så en levetid på omtrent 120 dager i blodbanene. For å kunne produsere hemoglobin og røde blodceller, trenger kroppen jern, vitamin B12, folat og næringsstoffer fra maten du spiser.
Vanlige årsaker til anemi er:
Jernmangelanemi
Jern er et mineral vi får i oss gjennom kosten. En barnekropp i vekst har relativt større behov for jern enn en voksen. Morsmelk inneholder lite jern.
Ved fødselen har vi med oss et "lager" med jern, slik at jernmangel ikke er noe problem det første halve året, selv om barnet bare får morsmelk. Dette lageret tømmes etter omlag 5-6 måneder. Risiko for å utvikle jernmangel hos spedbarn foreligger ved langvarig amming kombinert med ensidig kosthold.
Blant voksne er særlig kvinner i risiko for jernmangelanemi. De mister månedlig noe blod - og dermed jern - under menstruasjonen. Hvis de ikke har et kosthold som er rikt på jern, eventuelt de tar jerntilskudd, så kan det over tid oppstå jernmangel og anemi.
Les mer om jernmangelanemi.
Mangel på vitamin B12 og/eller folinsyremangel
Skyldes vanligvis nedsatt opptak i magetarmkanalen på grunn av annen sykdom. Vitamin B12 og folinsyre/folat er nødvendig for å danne blant annet røde blodlegemer (som inneholder hemoglobin). Ved mangel på vitamin B12 eller folinsyre, vil det bli dannet færre røde blodceller og dermed mindre hemoglobin.
Les mer om mangel på vitamin B12 og folinsyremangel.
Anemi ved kroniske sykdommer
Kroniske betennelsessykdommer, revmatiske sykdommer, nyresvikt, leversykdommer, sykdommer i magetarmkanalen og lavt stoffskifte kan påvirke produksjonen av røde blodceller og føre til anemi.
Les mer om anemi ved kronisk sykdom.
Aplastisk anemi
Det er en sjelden, livstruende anemi som skyldes at beinmargen svikter og ikke klarer å produsere nok av verken røde blodceller, hvite blodceller eller blodplater. Årsaken er infeksjoner, medikamenter og autoimmune sykdommer.
Les mer om alpastisk anemi.
Anemi ved beinmargssykdom
En rekke sykdommer som leukemier og myelodysplasier kan forårsake anemi ved å hemme blodproduksjonen i beinmargen. Virkningen av disse kreftsykdommene eller kreftliknende sykdommer varierer fra en mild endring i blodproduksjonen til totalt opphør av blodproduksjonen.
Hemolytiske anemier
Denne anemitypen oppstår når røde blodceller ødelegges raskere enn beinmargen klarer å erstatte dem. Visse blodsykdommer kan føre til økt ødeleggelse av røde blodceller. Hemolytiske anemier kan være nedarvet, eller de kan oppstå senere i livet.
Les mer om hemolytiske anemier.
Symptomer på anemi
Symptomer på anemi varierer med årsaken, men vanlige symptomer er:
- Slapphet
- Blekhet
- Kortpusthet
- Hurtig puls
- Svimmelhet
- Kalde hender og føtter
- Hodepine
Ofte oppstår anemi gradvis og over lengre tid. Tidlig i utviklingen av tilstanden merkes lite symptomer, men de tiltar etter som anemien forverrer seg. Ubehandlet kan anemier forårsake en rekke komplikasjoner, som:
- Uttalt slapphet. Ved uttalt anemi vil du bli så sliten at du ikke oker å utføre dagliglivets ordinære oppgaver. Du kan være for sliten til å arbeide eller leke.
- Hjerteproblemer. Anemi kan føre til rask puls eller uregelmessig hjerteaksjon, en arytmi. Hjertet må pumpe mer blod for å kompensere for mangelen på oksygen i blodet når du er anemisk. Det kan i noen tilfeller føre til hjertesvikt.
- Død. Noen nedarvede anemier, som sigdcelleanemi, kan bli alvorlige og føre til livstruende komplikasjoner. Tap av store mengder blod ved blødning fører raskt til akutt, alvorlig anemi og kan være fatal.
Diagnostikk av anemi
Ut fra sykehistorien vil legen prøve å utelukke andre årsaker til symptomene og finne den underliggende årsaken til anemien. Legen vil foreta en fysisk undersøkelse og særlig inspisere huden, lytte på hjerte og lunger, kjenne på leveren og milten i magen.
Blodprøver er nødvendige. Foruten blodprosent/Hb måles antall hvite blodceller og blodplater. En rekke andre blodprøver kan bidra til å kartlegge nøyaktig hva slags type blodmangel du har. Mikroskopi av blodet kan gi nyttige hint om hva årsaken er.

Andre undersøkelser kan også være påkrevd. For eksempel kan jernmangelanemi skyldes kronisk blødning fra sår (f.eks. i magesekken), polypper i tykktarmen, kreft i tykktarmen, svulster eller nyresvikt. Det kan være nødvendig å rekvirere undersøkelser som avklarer om slike sykdommer er den underliggende årsaken.
Behandling av anemi
Behandlingen er avhengig av årsaken til anemien. Ved jernmangelanemi må jernlagrene fylles opp, dels ved inntak av jerntilskudd og dels ved et riktigere kosthold:
- C-vitaminholdige matvarer (øker opptaket av jern)
- Matvarer med høyt jerninnhold er: Lever og kjøtt, mørkegrønne grønnsaker og grove kornprodukter
Dersom den underliggende årsaken til jernmangelanemi er tap av blod - unntatt menstruasjonsblod - så må blødningskilden finnes og stanses. Det kan innebære kirurgi.
Prognose ved anemi
Avhengig av grunntilstanden. Jernmangelanemi kan behandles med jerntilskudd.
Dette dokumentet er basert på det profesjonelle dokumentet Anemi hos voksne . Referanselisten for dette dokumentet vises nedenfor
- St. Olavs hospital. EQS kvalitetssystem. Hemoglobin i blod. data.stolav.no
- Fürst Medisinsk laboratorium. B-hemoglobin. www.furst.no
- McLean E, Cogswell M, Egli I, Wojdyla D, de Benoist B. Worldwide prevalence of anaemia, WHO Vitamin and Mineral Nutrition Information System, 1993-2005. Public Health Nutr. 2009;12(4):444-454. PubMed
- Anía BJ, Suman VJ, Fairbanks VF, Rademacher DM, Melton LJ 3rd. Incidence of anemia in older people: an epidemiologic study in a well defined population. J Am Geriatr Soc 1997; 45: 825-31. PubMed
- Artz AS, Fergusson D, Drinka PJ, et al. Prevalence of anemia in skilled-nursing home residents. Arch Gerontol Geriatr 2004; 39: 201-6. PubMed
- Zaiden R. Assessment of anaemia. BestPractice, last updated 08 Jan 2021.
- Bross MH, Soch K, Smith-Knuppel T. Anemia in older persons. Am Fam Physician 2010; 82: 480-7. American Family Physician
- Zakai NA, Katz R, Hirsch C, et al. A prospective study of anemia status, hemoglobin concentration, and mortality in an elderly cohort: the Cardiovascular Health Study. Arch Intern Med 2005; 165: 2214-20. PubMed
- Meneveau N, Schiele F, Seronde MF, et al.; Reseau de Cardiologie de Franche Comte. Anemia for risk assessment of patients with acute coronary syndromes. Am J Cardiol 2009; 103: 442-7. PubMed
- National Center for Health Statistics. Third National Health and Nutrition Examination Survey (NHANES III), 1988-94. Hyattsville, Md.: National Center for Health Statistics; October 1996.
- Allen LH. Causes of vitamin B12 and folate deficiency. Food Nutr Bull 2008; 29(2 suppl): S20–S37.
- Hagve T-A, Lilleholt K, Svendsen M. Jernmangelanemi – tolking av biokjemiske og hematologiske funn. Tidsskr Nor Legeforen 2013. doi:doi: 10.4045/tidsskr.12.0192 DOI